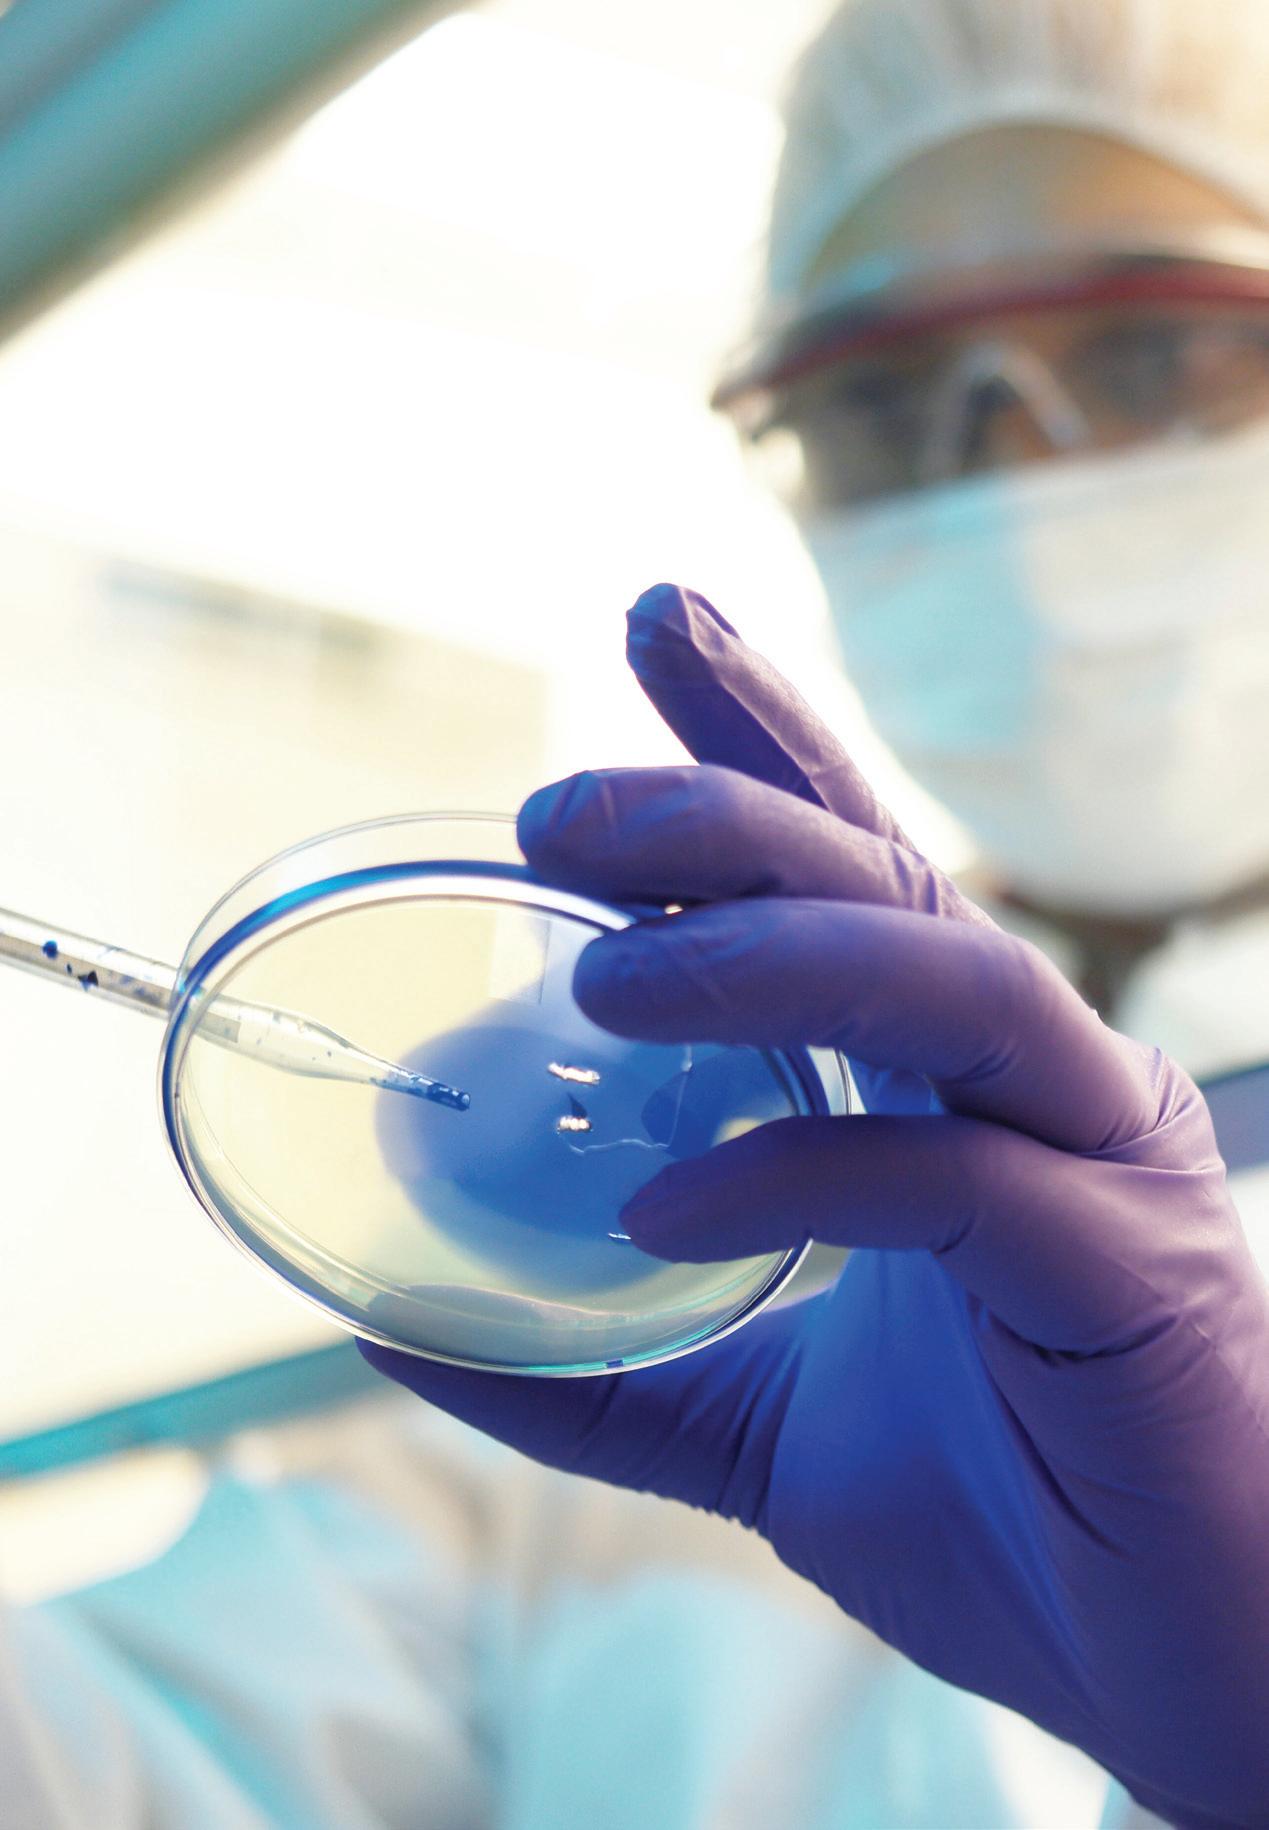

Autodesk adds AI to its list of ‘must-have technologies’ p.10
DESIGN
A quick primer on human factors analysis p. 18
FLUID POWER
Non-obvious causes of pneumatic tube degradation p.22


Autodesk adds AI to its list of ‘must-have technologies’ p.10
DESIGN
A quick primer on human factors analysis p. 18
Non-obvious causes of pneumatic tube degradation p.22

the country’s multiple advantages CAD REPORT

Designing efficient systems involves much more than simply understanding a few basic principles. There is a true art to balancing the specific requirements of an application in order to achieve the desired goals in the best possible way. Help us understand the unique needs of your application and together, we’ll develop something that surpasses what any of us could have done alone.
Contact your distributor to learn more, or clippard.com to request a free catalog and capabilities brochure.



Electronic Valves
Proportional Valves
Isolation Valves
Precision Regulators
• Toggle & Stem Valves
• Needle Valves
• Electronic Pressure Controllers
• Pneumatic Assemblies
• Special Manifold Designs
• Pneumatic Circuit Design
• Cylinders
• Fittings, Hose & Tubing


14 Six Ways To Unlock the Power of IIoT
How machine monitoring systems provide a new level of informed decision-making on the shop floor
18 Human Factors in Design
A quick primer on the human factors analysis philosophy of product design
20 Canada’s Innovation Paradox
Why Canada’s firms struggle to scale despite the country’s multiple advantages
22 Fluid Power
Non-obvious causes of pneumatic tube degradation and how to prevent them


6 Design News
unveils first EV muscle car and other engineering news
10 CAD Report Autodesk adds AI to ‘must-have’ technologies list at annual user conference.
28 Idea Generator
sensors






When I started as editor of Design Engineering in 2006, I have to admit I didn’t know much about mechanical engineering or Canada, for that matter. While I was born in Winnipeg, I grew up and started my career in Arizona before repatriating in my late 30s. Now, after 18 years with the magazine, I don’t pretend to grasp it all but I have learned a couple of things along with way, I think.
One is that Canada is an often overlooked pocket of awesome in a world that seems increasing chaotic. It’s far from perfect but, complain as we might about this or that, Canada is a notch above, especially to those who came from somewhere else.
I’ve also learned that it’s endlessly inventive. So much so, in fact, that I’ve often wondered why it isn’t filled with more heavy-weight companies like Ski-Doo inventor BRP, automation giant ATS and space robotics legend MDA.
As this issue’s cover story investigates, part of the reason is Canada’s close tie to the U.S. While an endlessly reliable source of trade, it can also be a predatory presence. Too often, promising start-ups with a clever idea get gobbled up by deep pocketed firms south of the border who take that potential and valuable IP with them.
The trick then is to make Canada a place where it’s more profitable to scale up than cash out. But, for a country with the population of California and the GDP of Texas, resisting the allure of the States and competing head-on may only work for a handful. Instead, to paraphrase NGen CEO Jayson Myers, it’s when Canadian companies collaborate, pooling their respective talents and resources toward a common goal, that they substantially improve their chances of turning invention into financially rewarding innovation.
The other thing I know is that, among editor gigs, it’s hard to beat a magazine like Design Engineering. There isn’t another I can think of with more varied or more “cool factor” subject matter. During my run, I’ve had the chance to work with great people and interview brilliant engineers and entrepreneurs at the forefront of their fields.
However, this issue is my last with the publication. My decision to move on hasn’t been an easy one and I’ll probably remain engaged with the subject matter in some capacity in the future. But even if I don’t, I know that it has been a pleasure serving the Canadian mechanical engineering community for nearly two decades. Thank you for listening.
MIKE MCLEOD Editor mmcleod@design-engineering.comEditorial Board
 DR. ALAIN AUBERTIN
DR. ALAIN AUBERTIN
President & CEO, Canada Consortium for Aerospace Research and Innovation in Canada (CARIC)

DR. MARY WELLS, P.ENG
Dean, Faculty of Engineering / Professor, Mechanical and Mechatronics Engineering; University of Waterloo

AJAY BAJAJ, P.ENG
President and CEO, Rotator Products Limited; Past President and Board Member, Power Transmission Distributors Association (PTDA)

DR. ISHWAR PURI, P.ENG
Vice President of Research; Engineering Professor, University of Southern California
MARCH/APRIL 2024
Volume 69, No.2 design-engineering.com
READER SERVICE
Print and digital subsciption inquiries or changes, please contact
Angelita Potal
Tel: (416) 510-5113
Fax: (416) 510-6875
Email: apotal@annexbusinessmedia.com
Mail: 111 Gordon Baker Rd., Suite 400, Toronto ON M2H 3R1
SENIOR PUBLISHER Paul Burton (416) 510-6756 • pburton@annexbusinessmedia.com
ASSOCIATE PUBLISHER Kathryn Swan (416) 510-6757 • kswan@annexbusinessmedia.com
EDITOR Michael McLeod (416) 442-5600 ext. 3231 mmcleod@design-engineering.com
NATIONAL ACCOUNT MANAGER Ilana Fawcett (416) 829-1221 • ifawcett@annexbusinessmedia.com
ACCOUNT COORDINATOR Cheryl Fisher (416) 510-5194 • cfisher@annexbusinessmedia.com
AUDIENCE DEVELOPMENT MANAGER
Beata Olechnowicz (416) 510-5182 • bolechnowicz@annexbusinessmedia.com
CEO Scott Jamieson sjamieson@annexbusinessmedia.com
Design Engineering, established in 1955, is published by Annex Business Media, 5 times per year except for occasional combined, expanded or premium issues, which count as two subscription issues.
Printed in Canada
Publications Mail Agreement #40065710
ISSN: 0011-9342 (Print), 1929-6452 (Online)
Subscriber Services: Canada: $58.65 for 1 year; $94.35 for 2 years;
Outside Canada: USA - $143.31; Overseas - $154.02; $10.00 for single copy.
All prices in CAD funds.
Add applicable taxes to Canadian rates.
From time to time we make our subscription list available to select companies and organizations whose product or service may interest you. If you prefer not to receive this information, please contact our circulation department in any of the four ways listed above.
Annex Business Media Privacy Officer: privacy@annexbusinessmedia.com
Tel: 800-668-2374
No part of the editorial content of this publication may be reprinted without the publisher’s written permission.
©2024 Annex Business Media. All rights reserved. DE receives unsolicited features and materials (including letters to the editor) from time to time. DE, its affiliates and assignees may use, reproduce, publish, re-publish, distribute, store and archive such submissions in whole or in part in any form or medium whatsoever, without compensation of any sort. DE accepts no responsibility or liability for claims made for any product or service reported or advertised in this issue. DE is indexed in the Canadian Business Index by Micromedia Ltd., Toronto, and is available on-line in the Canadian Business & Current Affairs Database.
































































Push-to-Connect Fit tings starting at $3.75/5 pk. (PLUG532)
NITRA pneumatic push-to-connect fittings are easily installed and work well with flexible tubing to make sealed connections.
• Threaded connections available with NPT, G-thread, and BSPT R-thread types
• Union-style fittings
• Available in thermoplastic, nickel-plated brass, or stainless steel bodies
• Configuration options include male straight (hex and round body), bulkhead female, long male elbow, tee reducers, and much more
• High working pressure and temperature
• Threaded elbow and tee fitting bodies can be rotated after installation

Starting at $86.00 (HVS-5211)


NITRA ISO 5599 valves are a robust directional air control solution that conforms to the ISO 5599/1 standard. They are sold as separate components, so you can buy what you need to replace existing equipment or purchase all the components needed to build a new system.
• ISO 5599/1 sizes 1 and 2 are interchangeable with all other brands meeting the ISO 5599/1 specification
• 5-port / 2-position and 5-port / 3-position valves available
• Solenoid coils sold separately in 12 & 24 VDC and 24, 110, & 220 VAC options





Flexible Pneumatic Tubing starting at $17.00/100 ft. (N532BLK100)

Strong, kink-resistant NITRA straight flexible tubing is available in a range of diameters and colors in 100ft packages or 500ft reels.
• Inch (up to 1/2in) and metric (up to 12mm) outside diameter tubing sizes
• Multiple colors available including black, clear, and dark green UV stabilized
• Straight polyurethane tubing
• Straight nylon 12 tubing
• Straight PTFE tubing
• Order stand-alone bases or manifolds separately
• Bases and manifolds are available in either G-thread (BSPP) or NPT thread types

• Straight bonded polyurethane tubing
• Made in the USA

In March, Stellantis announced that the Dodge brand’s first all-electric car models, the 2024 Dodge Charger Daytona Scat Pack and Charger Daytona R/T, will be assembled in the automaker’s Windsor Assembly Plant, starting in mid-2024.
The company says the iconic muscle car will also come in a traditional gas powered version, the Dodge Charger SIXPACK, produced in Windsor starting in early 2025. According to the company, both propulsion models align with Stellantis’ Dare Forward 2030 strategic plan intended to cut its global carbon footprint by 50 per cent by 2030.
Built on the company’s STLA Large platform, both BEV models will feature a 400V propulsion system with a nickel cobalt aluminum (NCA)-based battery that delivers 100.5 kW of capacity and a peak discharge rate of 550 kW. The battery is paired with a front and rear electric drive modules (EDM) – a combination of inverter, gearbox and motor – each of which is capable of 335 horsepower (250 kW) and 300 lb.-ft. of torque.
The Scat Pack and R/T variants diverge in terms of performance, the company says. The Daytona R/T will feature a Direct Connection Stage 1 upgrade kit that adds 40 horsepower over base output to reach 496 horsepower, the company says. The higher-end Daytona Scat Pack will feature a Stage 2 kit that unlocks total output to 670 horsepower. According to Stellantis, the Scat Pack variant is expected to reach 0-100 km/h in 3.3 seconds and a quarter-mile of roughly 11.5 seconds.
The ICE models will include the Dodge Charger SIXPACK H.O. variant with a 3.0L Twin Turbo Hurricane engine producing 550HP and the

standard output Dodge Charger SIXPACK S.O., fueled by a 420-horsepower 3.0L Twin Turbo Hurricane engine.
While driving range may not be the first consideration among muscle car owners, both electric models will incorporate a variable regenerative braking system – adjustable using paddle shifters – to help each model achieve their typical range: 510km (R/T) and 418km (Scat Pack). Both vehicles, Stellantis says, can be recharged from 20 to 80 percent

in approximately 27 minutes when using a Level 3 DC CCS fast charger.
www.stellantis.com
The Women’s Executive Network (WXN) has named Mary Wells, Dean of Waterloo Engineering and professor in the Department of Mechanical and Mechatronics Engineering, as one of Canada’s most powerful women.
WXN’s annual award celebrates 100 outstanding women across Canada who make a transformational difference in their fields and actively shape a more inclusive future.
Dr. Wells was recognized along with 11 co-winners under the Canadian Tire Community Impact Award category, which celebrates women from many sectors, including education, who embrace community outreach and amplify underrepresented voices.
In addition to being an award-winning researcher of advanced metallic alloys for use in the automotive and aerospace sectors, Dr. Wells has led national initiatives to create engineering
The 2024 Dodge Charger Daytona Scat Pack (left) and Dodge Charger Daytona R/T, the first all-electric vehicles from the Dodge brand, will be built in Stellantis’ Windsor Assembly Plant, starting in mid-2024.opportunities for women and other underrepresented groups.
She has served as the Associate Dean of Outreach for Waterloo Engineering and chaired its Women in Engineering committee. She also chaired the Ontario Network of Women in Engineering and is a founding partner of the Indigenous & Black Engineering Technology PhD Project. wxnetwork.com
The European Space Agency (ESA) launched the first metal 3D printer to operate in space in January. Under contract to the ESA, Airbus Defence & Space
Samples produced by the Metal 3D Printer, developed by Airbus and AddUp, prior to launch to the International Space Station.

developed the unit – plainly named the Metal 3D Printer –along with French metal additive manufacturing OEM, AddUp.
The Metal 3D Printer was designed to test 3D printing’s ability to perform metal disposition under sustained microgravity conditions. The printer uses stainless-steel wire as the build material, which is melted using a high powered laser.
The printer will be installed in the ISS’ Columbus European Science Module, alongside other experiments carried out by European teams. During its time on board the ISS, it will produce four prints, each taking two to four weeks to finish. The four parts will then be returned to Earth and compared with the parts printed by the same machine on Earth before launch.
The ESA’s aim is to increasing the self sufficiency of the space station by enabling astronauts to manufacture spare parts directly in space. The technology could also reduce the prohibitive transport costs of delivering spare parts from Earth, which can take up to 12 months to arrive.
www.airbus.com addupsolutions.com






Ottawa-based engineering services firm, Calian Group Ltd., announced it has acquired MDA Ltd’s nuclear services assets. Best known for the Canadarm2 and RADARSAT, MDA has also provided engineering services to the Canadian nuclear industry, delivering project planning and management for large nuclear outages and refurbishment projects.
According to Calian, MDA’s nuclear team will be integrated into the company’s existing nuclear business within its Advanced Technologies segment.
“The MDA Nuclear team will add new capabilities and services to Calian’s existing nuclear business,” said Calian CEO, Kevin Ford. “The Calian Nuclear team is growing, with new projects and opportunities across Canada and globally, and we’re thrilled to accelerate our growth through this powerful addition to our team.”
Calian says the addition of MDA’s nuclear team will strengthen its ability to serve a mutual client, Bruce Power, as well as better support operations and refurbishments of existing nuclear facilities. www.calian.com mda.space/en/
Kraken Robotics announced it has completed delivery of its mine-hunting sonar equipment under contract with the Danish Ministry of Defence Acquisition and Logistics Organization (DALO) and its minehunting sonar upgrade program.
In total, the Newfoundland-based company has

delivered four turnkey mine-hunting systems, each consisting of its KATFISH towed Synthetic Aperture Sonar, Tentacle Winch and Autonomous Launch and Recovery System (ALARS), plus equipment for command and control, and remote operation and monitoring.
Starting in 2022, the KATFISH mine-hunting systems were integrated onboard the Royal Danish Navy’s MSFclass uncrewed surface vessels (USVs). Kraken also integrated the KATFISH system with
Saab’s Command and Control (C2) software and Kongsberg’s Maritime Broadband Radio (MBR) for remote operation.
In 2023, Kraken also entered into a 7-year sustainment contract with DALO, that includes maintenance, repair and overhaul, as well as provision of training, spare parts and software updates. Throughout 2024, Kraken says it will also deliver additional spares, including spare towcables and two spare KATFISH towbodies.
krakenrobotics.com
Synthetic
 Kraken Robotics’ KATFISH towed
Aperture Sonar aboard two of the Royal Danish Navy’s MSF-class uncrewed surface vessels.
Kraken Robotics’ KATFISH towed
Aperture Sonar aboard two of the Royal Danish Navy’s MSF-class uncrewed surface vessels.


Realize your vision with Festo’s approach to smart automation. Partner with Festo today.

For the past few years, the theme of Autodesk University (AU) has focused on how the future is uncertain, but Autodesk will save you from that uncertainty – if you allow it to.
“Though the uncertainty we are facing is increasing, so is the technology available to us... Ignore this disruption and you risk getting left behind,” warned Autodesk CEO Andrew Anagnost during his keynote address at AU 2023.
The year before, during AU 2022, Autodesk wanted manufacturers to replace their existing systems with a new all-encompassing cloud service. The year before, manufacturers were instructed that digital collaboration was now a necessity. Before that, it was the need for the death of the local computer file. As I look around today, the file remains strong, drafting has been digitally transforming since the 1980s, and cloud services have been assisting users since the 2010s.
Most recently, the company has touted Autodesk AI, an artificial intelligence platform that intersects with Autodesk’s online design software, as the latest “must-have” solution. Quoting a study Autodesk commissioned in 2022, 78% of customers polled are more worried now than at the height of Covid-19, Anagnost said. For Autodesk, AI is the cure for that anxiety. “We’ve gone from talking about the promise of AI, to seeing it make real progress,” he said.

These words, spoken optimistically last November from the big stage in Las Vegas, came just as dozens of lawsuits challenged the firms that develop LLM-based generative AI, alleging they were feeding on copyrighted material, without prior consent or compensation, to power their large-language models.
In the few months since AU 2023, we’ve seen modern AI software, most notably Google’s Gemini, generate images of historical figures – including popes, Vikings and German WWII soldiers, “in a variety of ethnicities and genders,” according to The Guardian. Similarly, Fortune Magazine reported that Microsoft’s Copilot chatbot has been giving users “bizarre and disturbing answers.” In addition, multiple outlets reported that several AI systems struggled to provide accurate information on voting-related questions.
Most recently, the company has touted Autodesk AI, an artificial intelligence platform that intersects with Autodesk’s online design software, as the latest “must-have” solution.
Never mind. Autodesk plans to make its AI help designers become more agile and more creative, by analyzing data, gaining insights from it and automating non-creative tasks.
“There is no AI without actionable data,” explained Raji Arasu, Autodesk’s chief technology officer. That data Autodesk AI needs to feed on is your intellectual property, 40 petabytes of which you’ve uploaded to Autodesk’s cloud. The legal ramifications have yet to be fully worked out, notes AEC Magazine editor Martyn Day, but you will be nudged to share.
“We have to get people comfortable with how much of your data you want to share with the greater good, versus what you want to keep for your own proprietary abilities,” Day quoted Anagnost as saying during an AU press conference.
For the keynote example, executives went to car manufacturing, which is odd, given that Autodesk has little presence in that field, other than in automotive styling. Nevertheless, electric vehicle
makers, such as Rivian, are well-suited as examples of new, small companies producing complex products. Rivian uses Autodesk’s VRed for vehicle styling and Fusion for CNC manufacturing, along with Construction Cloud for managing its buildings.
“What an incredible glimpse into the disruption happening in automotive,” enthused executive VP of design and manufacturing Jeff Kinder, speaking of Rivian. “The automotive industry has reached a tipping point, but a tipping point is coming to all your industries.”
Perhaps not quite yet. Soon after AU, poster-child Rivian laid off staff in early 2024 and lowered production estimates amid worsening losses. “Change seems certain, until something unforeseen happens,” explains Digital Darwinism author, Tom Goodwin.
What’s New in Fusion
At AU 2023, Autodesk also re-emphasized the abilities of Fusion Cloud – a centralized database residing on remote

servers that distributes uniform sources of information to users. It is meant to handle everything from the design studio through to the shop floor, giving real-time access to designs, simulations, electronics, manufacturing and factory operations. Note that Fusion Cloud is a work in progress.
New in Autodesk’s Fusion MCAD software are configurations that can
generate multiple variants of the same product, something competitors have had for quite a while now. Rather than create new model files, however, Fusion records the variations to a cloud database, which could make variants easier to manage.
Autodesk is counting on AI to automate repetitive processes in Fusion, such as making initial designs, creating documentation and operating the shop floor. For example, Autodesk acquired BlankAI for its AI-based car shape design







software, which will digest your previous automobile styles and then generate new ones. Soon, the company says, AI will also translate 3D models into fully-dimensioned 2D drawings “with the click of a button.” In CAM, the time to generate tool paths might get up to 80% faster using AI analysis, Autodesk says.
To handle factory floor communications, Autodesk in 2022 acquired ProdSmart for scheduling and tracking production. Last year, it acquired FlexSim for 3D simulations of manufacturing facilities, warehouses and even health facilities, complete with simulation of workers’ movements.
Fusion supports software from other vendors, too. In 2022, Fusion was linked with Ansys (acquired by Synopsis in January 2024) for its signal integrity analysis for PCB designs. Last year, support for Cadence was added to take advantage of its electrical design software. Changes made in any of those programs are updated in the others.
For Fusion in 2024, Autodesk plans to emphasize cloud data collaboration, core capabilities and AI with automation. In CAM, for instance, there will be advanced touch/avoid milling strategies, and additional support to eliminate gouges and collisions. To try out new

functions early, users can sign up for the Fusion Insider program.
Autodesk would love users to replace Inventor with Fusion. The company made no mention of Inventor during the keynote, even though the venerable MCAD program hit a milestone this year by turning 25. Nevertheless, Autodesk does continue to update it.
Here are some of the new functions. The browser has a new Finishes folder that specifies material coatings and surface finishes – such as polished aluminum or case hardening – on faces, parts, assemblies and manufacturing processes.
Elbows in Inventor are no longer limited to just 45- or 90-degrees, and you can also define elbow styles. Sketches, like text, can be wrapped and projected onto
non-planar faces. 3D weld symbols are now a 3D annotation type. Revolved faces can define the axes of patterns. In addition, patterns now have incremental and fitted positioning methods.
Inventor can also now send IPT part files to Fusion 360 for creating manual inspection tasks. Models shared between Inventor and Fusion 360 can send alerts that they might need to be updated, following changes to one or the other.
Autodesk has repeatedly stated it has been working on AI for “over ten years” by redefining generative design as AI. However, despite the decade-long headstart, the company doesn’t seem to have decade-long results to show. AI-powered automated drawings, for example, were promised by the end of 2023; now they are “arriving very soon.”
Autodesk promises that “Done well, [AI] has the transformative power to understand and address the capacity [constraint] issues all of you face.” But who checks the inputs to, processing of, and outputs from AI? The foundations of engineering are facts, not promises. By opening the AI Pandora’s Box, we get the bad along with the good: Security researchers last month designed an AI text input that generates worms to steal data stored by AI systems.
CAD is a mature sector, and so vendors hunt for new services to provide new revenues. During AU, executives declared several times: You need to change the way you work. To my ears, this sounds like they were disguising an appeal: Please buy our new software.
I’d argue that the best person to know how you need to work is you. As longtime technology commentator Andrew Orlowski encourages us, “‘Everything you know is wrong’... was 0u8. Lots of things you know are actually right, because you’ve worked them out through reasoning or experience. They have not suddenly become wrong.” |DE
Ralph Grabowski writes on the CAD industry on his WorldCAD Access blog (www. worldcadaccess. com) and has authored numerous articles and books on CAD and other design software.
Autodesk has repeatedly stated it has been working on AI for “over ten years.” However, despite the decade-long headstart, the company doesn’t seem to have decade-long results to show.

We
OPTIME ™
enables me to keep an eye on hundreds of machines in just a few hours – which makes OPTIME a quick, easy and economical condition monitoring solution.
www.schaeffler.ca/optime


How machine monitoring systems provide a new level of informed decision-making on the shop floor.BY MARK BACKUS
Connected technologies are creating powerful opportunities for the manufacturing industry. The Industrial Internet of Things (IIoT) enables connected machine monitoring and offers new possibilities for transparency, efficiency and productivity.
The integration of IIoT throughout the metalworking process, for example, can create more actionable and valuable data in real time than ever before. That data can then be aggregated and analyzed in a centralized machine
monitoring system to help identify inefficiencies or potential failures before they become a serious problem. This powers a new level of informed decision-making on the shop floor and in the engineering room, allowing operations to minimize downtime, optimize processes and prove out tool paths for new parts.
But this digital transformation isn’t happening at the same pace in every workshop. Keeping up with technological change can be challenging, especially when there are quotas to fill and tight
deadlines to meet. Let’s look at some parallels from metalworking that can help other shops navigate the ever-evolving technological landscape — no matter where they are on the digital transformation journey — to find the right tools, strategies and partners to innovate their business.
When shops only depend on the red, yellow and green andon lights to understand the status and utilization of their operations, they’re not making the best use of the data their machines are generating. A red light only tells a small part of the story to an operator. It doesn’t tell them whether the machine has crashed, engineering is doing a test or the machine is out of work material.
To solve for this, some companies use in-house analytics that take historical data exported from machines to assess their processes. But addressing problems after the fact severely limits opportunities for improvement.
Connected machine monitoring systems may provide a more useful solution, providing real-time, in-depth analytics of the data underlying red, yellow and green andon lights of a specific operation. A metal cutting shop may analyze its machine data based on custom rules established in collaboration between the condition monitoring software provider and the machining operation.
These rules can follow industry-standard measurements for overall equipment effectiveness (OEE), incorporating factors such as machine utilization, availability performance and production quality. These platforms are designed to capture and report the kind of data crucial for machining operations to sustain their continuous improvement and lean manufacturing efforts.
With IIoTenabled machines, operators gain the insight needed to identify and reduce waste in their processes.
The earlier you start saving with the Engineers Canada-sponsored Financial Security Program’s registered retirement savings plan (RRSP), the more you’ll save.
Ok, we know that’s not exactly rocket (or geo) science – but do you know how much more you can save? It really adds up!
Want some advice? Connect with your personal Canada Life health and wealth consultant online when it’s convenient for you at all steps of your financial journey.
2. Pinpoint your pain points.
A shop has a lot of machines generating a lot of data, but how do operators determine which data to focus on to make the best use of condition monitoring software? The first step is to identify persistent issues or bottlenecks – waste, unscheduled downtime, quality issues with specific parts or machines – that require more complete data to implement root cause analysis.
For example, many shops find their operators spend more time doing setup than actually machining parts.The right condition monitoring software can be configured to track key parameters, such as setup times; part loading/ unloading time; and time spent on fixture changes, tool changes or blow-off cycles, among others.
Today’s machining condition monitoring platforms let users easily configure and track these data points and zero in on where time is being wasted and assets underutilized. More importantly, the data is more accurate and available in real time, enabling users to make informed operational changes or business decisions quickly and with confidence.
3. Use IIoT to get data at the tool level.
It isn’t just your machines that can provide useful data. Shops that want to take data-driven production to the next level can also start collecting data at the tool level.
Incorporating sensor-equipped driven tool holders and turning adapters on a metal cutting machine, for example, provides insight where the work takes place. With embedded sensors, a smart driven tool holder system can measure variables like cutting forces, torque, vibration, temperature and real RPMs, showing the exact number of hours spent in production. This data can also be transmitted wirelessly to a central monitoring system to extract more valuable insights.
With embedded sensors, a smart driven tool holder system can measure variables like cutting forces, torque, vibration, temperature and real RPMs.


A machine monitoring platform also provides insights on machine utilization and performance, as well as machine and tool availability.
With a sensor-enabled driven tool holder solution, the system can also detect early signs of tool wear or potential failures, allowing for more proactive tool replacement or adjustment to prevent unplanned downtime. For example, if the connected tool holder system detects an unusual increase in cutting forces or excessive vibration, it sends an alert to the operator
or maintenance team, notifying them of the need for an inspection or tool replacement.
Another example at the cutting tool level is the use of an intelligent turning adapter for deep boring bars. These sensor-equipped adapters use intelligent damping technology to minimize vibration while optimizing metal cutting operations. By integrating IIoT capabilities, they can offer

real-time insights into machining processes and enable operators to make data-driven decisions for improved productivity and tool life.
These smart adapters can also interface with a machine PLC and provide valuable information on tool condition, machining parameters and process stability. By analyzing vibration patterns and comparing them against predefined thresholds, the system can identify deviations that indicate tool wear, improper tool setup or unstable cutting conditions.
Cloud-based condition monitoring platforms offer multiple advantages compared to systems that must be installed and networked on servers at your operations. Many of the more recent machine tools have high-speed Ethernet-based interfaces that simplify the process of connecting tools and production floors to external networks and cloudbased applications.
The kind of complex, real-time analysis and reporting provided
by these condition monitoring programs utilize advanced algorithms and significant processing power, which the cloud is much more able to support than on-premise servers. Cloud-based solutions offer the ability, from literally anywhere in the world, to see not only the current state of machines but also how those machines have performed since the first day they were connected.
With a cloud-based solution, data is protected behind firewalls, with condition monitoring providers offering systems that typically comply with strict government security protocols covering sensitive defense and intelligence applications. A cloud-based application is managed and kept up to date by the platform provider. This means the shop’s IT department is not required to maintain expertise in managing and updating this kind of application.
5. Use your machine analytics platform as an engineering tool.
Beyond maximizing uptime in day-to-day production, machining insight platforms can play a
big role in proving out processes to machine new parts. With the right platform, engineers can track new tool paths and cutting forces in real time, giving them up-to-the-minute insight on what is and isn’t working in a process. Engineers can use this insight to develop new machining methods for new parts more quickly, and even remotely.
The data is accurate enough that an engineer can determine, on the spot, whether they need to try a different tool, change an insert or use a new tool path to improve the process. The result can mean big improvements for new product setup. What might otherwise take a week of on-location engineering time and nearly half a dozen test parts can now be accomplished in one or two days with just one or two parts.
Cloud-based
6. Choose a partner, not just a platform.
There are many condition monitoring software platforms available that are developed for general industrial applications. However, these platforms may not offer the level of insight or support needed for the unique demands of the metal cutting industry. Finding a platform from a manufacturer with indepth expertise in your specific industry will mean the system will be configured specifically for machining data.
Beyond the software, an expert condition monitoring partner who knows your industry will be able to provide essential advice and technical support throughout your digitalization journey. From planning and implementation to data analysis and other support services, the right partner can guide shops to quicker returns on a digital machining investment. |DE
Mark Backus is the Regional Product Manager for Machine Integration/ Tooling Systems, Americas, Sandvik Coromant.

To the consumer, products arrive in the world fully formed. Rarely, if at all, do they think about the series of steps that brings a given product from someone’s imagination to their living room. And if they are thinking about those steps, it almost always means the product designer has done something wrong.
That’s because the ideal outcome, for the product designer, is that their end-users never think of them at all. The consumer simply uses their product, happily, without complications or complaints, until it’s lost or broken.
BY KEVIN BAILEYOf course, it takes an extraordinary amount of work to produce that degree of satisfaction in the consumer. Even the simplest product needs to be analyzed, and tested from every angle, before reaching the consumer’s hands. As it happens, the philosophy underlying this process has a name, well-known to every product designer: Human factors analysis.
What is human factors analysis? On a simple level, it’s the way that product designers guarantee their products will function as intended in the real world. No product exists in a vacuum—they are handled by specific people, with specific
Let’s start with the physical aspect. This refers, on a basic level, to a product’s ergonomics—its size and shape, its materials, and also (in the case of Calibre) how it feels when it’s strapped to your face.
For Calibre, we knew we needed the device to be aesthetically pleasing. It also needed to be lightweight and functional, so people would actually be inclined to wear it.
That meant conducting human anthropometrics analysis of facial structures. It meant testing user after user for face fit and taking detailed notes. Straps were rapidly iterated and prototyped for maximum comfort and functionality; airflow dynamics testing was conducted to ensure that Calibre stayed comfortable even at high breathing rates.
The final product packs a suite of gas and pressure sensors into a tiny, portable wireless electronic module which – crucially – clips comfortably to the face.
needs and skill-sets, in specific environments at specific times. Human factors analysis is a way to account for all of those variables—to ensure that a given product will actually work when it reaches store shelves.
Let’s use a concrete example: Calibre, a real-time wearable fitness metabolic performance tracker. The following will take you, stepby-step, through the human factors analysis process as it applied to our development of Calibre, along the way hopefully providing a clearer picture of how human factors analysis impacts product design generally.
Now we move on to the cognitive aspect. This refers to every bit of mental activity that surrounds the consumer’s purchase, use, maintenance and disposal of your product. It means not only the mental steps a consumer needs to take to properly interact with your product—it also means how taking those steps makes the user feel. Do they find the experience empowering or frustrating? Can they access your product’s features intuitively and with ease, or do they have to pause and think it through, or give up trying?
But the cognitive aspect also encompasses the user’s awareness of what they can actually get out of your
product. In Calibre’s case, that meant its ability to provide meaningful, reliable data that can improve everyday health and performance. The “cognitive experience,” here, is more detailed information about your body and your health. In designing Calibre, then, we were hyper-conscious of foregrounding those features and making sure end-users would understand, with minimal effort, how to fully access and interpret them.
The social, cultural, and emotional aspects
The physical and cognitive aspects of a product are arguably the most important, but they comprise only a part of human factors analysis. Social, cultural, and emotional aspects can often be just as significant when it comes to widespread product adoption among a given target audience.
The social aspect refers to how others might perceive you in relation to the product. It encompasses the concerns that most of us have, as we go about our day—worries about fitting in, about looking weird, about being judged.
Obviously, a wearable electronic facemask will always look out of place on a subway car or a busy street unless a majority of people are wearing them. What mattered to us, though, was that our target customer—someone already inclined to exercise regularly and interested in new technology—would feel socially comfortable wearing it while working out, given they are early adopters. That concern would ultimately guide Calibre’s final form.
Then there’s the cultural aspect—fundamentally, this just means being intentional about who your product is

targeted towards. No single product can be optimally designed for every market in the world—inevitably, product designers will have to target one or more specific audiences. The task, then, is to make the design more neutral, to minimize cultural or other risks to attract a wider range of target consumers.
Finally, we have emotional factors. Oftentimes, products become a meaningful part of our lives—integral parts of our day-to-day experiences and even our identities. The ability to personalize a product is typically a reliable route to a consumer’s heart, but personalization also tends to be expensive on the production end.
With Calibre, of course, the hope is that the initial product human factors decisions for the wearable ensures it becomes a reliable part of the workout routine—something our target consumer couldn’t imagine going without. Future products can then provide diversity of color, style, form and functions to increase product adoption.
You can see, then, how human factors analysis guides every step of the product creation process: A product
would have wound up less comfortable, or less usable; at a minimum, it would have been less tailored to the needs of our target audience.
like Calibre developed only by engineering teams without user testing during the early stages of design would look and function very differently. Without the process of human factors analysis, the solution
Only by actual testing and iterating early in the process – while making fundamental product definition decisions by working with real people, the kinds of people we hoped to one day sell our product to – could we have made something that stood a chance of succeeding in the real world. You can think of human factors analysis, then, as a collaboration—the customer and designer guiding the engineering, working together to bring forth a product that could never have existed otherwise. |DE
Kevin Bailey is the CEO and Founder of the Ottawa-based product design firm, Design 1st.
 Developed in conjuction with Design 1st engineers, Calibre’s wearable performance tracker offers real time metabolic and respiratory metrics.
Developed in conjuction with Design 1st engineers, Calibre’s wearable performance tracker offers real time metabolic and respiratory metrics.
For economists, investors, political leaders and anyone who tracks the economic growth of nations, Canada poses a bit of puzzle. On the one hand, it has plenty going for it. Canada, for example, sports one of the world’s most educated workforces. According to the 2021 census, the percentage of 25- to 64-year-old Canadians with a college or university degree is a whopping 57.5% – a number that puts it at the top (as of 2022) of G7 countries, Statistics Canada says.
The country is also highly attractive to the world’s top minds, offering a substantially quicker path to residency than the U.S. In fact, highly educated immigrants account for a significant proportion of those Canadians with university degrees. Added to that, Canada boasts some of the world’s most highly regarded engineering and scientific research centers, (e.g. UofT, UWaterloo, McGill, etc, etc.) that show up on top international university rankings year after year.
Canada’s fertile ground extends beyond just talent and research. The Scientific Research and Experimental Development (SR&D), despite the complexity of its application process, still ranks as one of the most generous R&D tax credits in the G7. Throw in the NRC’s Industrial Research Assistance Program (IRAP),

According to the 2021 census, the percentage of 25 to 64-year-old Canadians with a college or university degree is a whopping 57.5% – a number that puts it at the top (as of 2022) of G7 countries, Statistics Canada says.
the Global Innovation Clusters (formerly Super Cluster), plus more narrowly targeted federal and provincial programs, not to mention non-profits like Mitacs and the MaRS Discovery District, and there no shortage of financial and advisory assistance for the entrepreneurial.
And yet, despite all its advantages, Canada struggles to capitalize on them. According to the Organisation for Economic Co-operation and Development (OECD), real per capita GDP in Canada grew less than 1% from 2007 to 2020.
Similarly, The Global Innovation Index’s 2022 report ranked Canada 15th of 132 nations in its innovation rankings, behind Germany, Finland, Denmark, Japan, and the United States.
In part, this disparity between inputs and outputs is amplified by one of Canada’s biggest strengths: Its proximity to the U.S. market. In their 2019 report, To Sell or Scale Up: Canada’s Patent Strategy in a Knowledge Economy, Canadian economics professors, Nancy Gallini and Aidan Hollis, conclude that the temptation for Canadian inventors (or their short-term oriented investors) to sell the IP to large, mainly U.S. firms is often too strong.Why risk scaling up in Canada, vying with much larger and wealthier U.S. competitors, when you can cash out during the initial stages of product development?
Nevertheless, Canada remains

one of the top spots internationally to start a company. The Toronto-Waterloo Corridor, for example, ranks as one of the largest tech hubs in North America. According to the Global Startup Ecosystem Report 2023, by innovation policy research firm Startup Genome, the corridor hosts 15,000 tech companies employing 250,000 tech workers, placing it in the top 20 of technology ecosystems globally.
Even so, most companies like these have struggled to scale historically, says Jayson Myers, CEO of NGen, the not-for-profit that oversees the advanced manufacturing Global Innovation Cluster. Over his nine years as President and CEO of the Canadian Manufacturers and Exporters Association (CME) and the past seven years

at NGen, Myers says he’s seen Canada’s innovation paradox play out repeatedly, first hand. While Canada succeeds at the input side of the equation, he says the output (i.e. commercialization) suffers from the lack of a key element.
“All the support for startups and tech is great, but there’s usually one thing missing, and that’s the customer,” he says. “Over my career, I’ve seen all sorts of programs to support research and push tech into the marketplace, but I just see it as like a train. You’ve got the engine, which is the customer, and then you’ve got service, manufacturing, tech, and then you’ve got research at the end. [Canada’s] approach has been to supercharge the caboose but then wonder why the train doesn’t move forward.”
As Myer’s analogy implies, what’s required to improve Canada’s economic performance is to focus on the demand side of the equation, supporting the end customer who in turn pulls the other components along. However, there are challenges to this approach. One, Myers says, comes down to marketing. As he puts it, in the Canadian market “nobody knows when anybody else is doing.” A larger challenge however, stems from the disconnect between technology companies and their potential customers.
“[Canada has] a problem around tech adoption, but it’s not just because manufacturers or industrial customers are risk averse,” he says. “It’s because the tech companies don’t offer them the solutions they need. Often, those solutions need to be packaged in an integrated engineering solution that can be managed by manufacturers that actually meet their requirements.”
As one of NGen’s principle architects, Myers says the solution to these challenges, and the organization’s purpose from the beginning, has been to build and support collaboration between technology companies and, in the case of NGen, manufacturers.
As a result, projects green-lit by NGen for funding are commonly a pairing of a manufacturing firm with a specific problem and one or more Canadian technology firms with a potential solution. NGen often plays match-maker for these collaborations, as well as consultant, providing feedback on the strengths and weaknesses applicants’ proposals.
“[Canada] has all this great tech and great startups but, in many cases, they don’t understand how a manufacturing customer would use their technology,” Myers says. “On the other hand, you’ve got manufacturers who aren’t necessarily aware of what technology exists, and if they are aware, they don’t see how they could use it to
improve their business.”
“What [NGen does] is integrate the technologies and research along with the manufacturer that has the problem,” Myers adds. “It’s that collaboration that, first of all, develops the unique manufacturing solution, but also generates the commercial opportunity. [NGen] bridges this chasm between the tech and the research on one side, and then the industry customer on the other. That, I think, is a very important part of what we do and a strategy that really pays off.”
And the payoff has been considerable, Myers says. At NGen’s N3 Summit in February, the notfor-profit announced that its first 165 cluster projects resulted in $7 billion in new sales for Canadian companies, a 32x return on $250 million worth of investments the organization made between 2019 and 2023 and a nearly five times return on federal tax dollars invested. To boot, NGen said 55 new companies and 3,449 new jobs were created as a result.
At the end of the day, the way out of Canada’s innovation paradox, Myers contends, is to help Canadian companies collaborate on solutions to existing problems.. The resulting partnership not only provides an ongoing organic source of income so tech companies can scale the business, but also provides a concrete usecase to show the next potential customer.
“A big part of what we do is meshing together an ecosystem and filling in gaps, such as management training, integrating manufacturing with entrepreneurship courses, attracting young people into advanced manufacturing careers and leading Canadian companies to international trade shows,” Myers says. “These are measures individual governments can’t do on their own, but where we can play a catalytic role. Often it takes just a small amount of investment but results in a huge payoff.” |DE

Because pneumatic tubing is a common component in machines, many designers don’t give it the attention it deserves. In reality, choosing the right tubing is a critical aspect of machine design, and your selection process must consider factors that extend beyond the more “obvious” operating conditions.
Given what’s at stake, it’s important to ask the right questions about your machine’s surroundings during the initial design process. Understanding both the obvious and less obvious conditions pneumatic tubing will be exposed to will inform the right choice of polymer
– whether polyurethane (PU), polyamide (PA) or polyethylene (PE), among others.
When it comes to tubing failure, 90 percent of customer complaints falls under environmental damage – including physical, chemical and microbial damage – compared to mechanical factors like rubbing or crushing.The reason for this disparity is due to the unforeseen dangers of certain environmental factors on the tubing.
For example, adding tubing to a machine located near windows can expose

the tube to damaging UV rays from sunlight. High-energy radiation – whether ultraviolet, X-ray or gamma radiation – will cause the tube’s macromolecules to split and lead to tubing deterioration. Such an oversight is completely accidental but can have long-lasting effects on not only the tubing’s lifespan, but also machine performance.
UV energy excites photons in plastics, a process that creates free radicals. In the presence of oxygen, these free radicals form oxygen hydroperoxides that
compromise the backbone chain and weaken the structure. Called photo-oxidation, this process can also cause a color shift on the surface of the tubing.
While certain polymers, such as polytetrafluoroethylene (PTFE), have excellent natural UV resistance, adding certain stabilizers, absorbers or blockers to the plastic is an effective way to prevent UV degradation. For example, the addition of carbon black can provide sufficient protection for outdoor applications.
In addition to UV rays, natural and artificial sources of water and moisture are other potential causes of environmental tubing damage. In general, ester-based PU tubes are susceptible to hydrolysis reactions that cause tubing degradation, while ether-based PU tubes offer greater hydrolytic stability, especially in humid environments. In general, it’s important to ensure the tubing used incorporates additives that resist UV radiation or hydrolysis, depending on your needs.
Heat can come from various sources, some of which may be more obvious than others. For example, perhaps you need to run tubing across a vehicle engine, in which certain components will become hotter than others. Throw a particular warm day into the mix, and the resulting high temperature may exceed what your tubing was initially designed to handle. Another common, though perhaps less obvious, source of heat is simple friction. If tubing runs up against components in a machine with high cycle rates, for example, then the frictional heat can build and cause the tubing to fail over time.
Much like temperature, pressure is a variable that requires you to consider conditions that may exceed the tubing’s normal range. For example, perhaps the machine you are designing incorporates a regulator that reduces a 200 PSI inlet pressure down to an acceptable operating pressure of 90 PSI. If the regulator fails, suddenly the whole system – your tubing included – will experience a damaging pressure spike.
In general, if you don’t design around

Results of Festo’s in-house weathering tests.
the maximum temperature or pressure the tubing can handle, then any spike in these conditions can cause fatal “ballooning.” PA, also called nylon, tubes are ideal for standard applications with increased pressure and temperature ranges, and many can withstand pressure ranges over 290 PSI.
Acids and bases can trigger chemical reactions in a tube’s polymer, causing its molecular structure to split, resulting
in radial cracks. To avoid this structural deformation, it’s important to select a polymer that can withstand chemical exposure – such as perfluoroalkoxy alkanes (PFA), which can handle even the most aggressive acids and lyes. Perhaps the most obvious industry where chemical interactions are a concern is food and beverage, which typically utilizes equipment that must endure washdown and other caustic cleaning chemicals.
But unfortunately, not every scenario is this obvious. For example, if you’re



running tubing near a machining tool that cuts metal, then it’s important to take into account the fact that some coolant may settle on the tubing. If that’s the case, chemicals within the coolant can react with the tubing material, leading to premature tubing failure.
In addition, standard PU tubing, if left in direct contact with electric wires or sensor cables in dark, humid environments, can experience chemical damage via phosphoric acid, which is found in phosphorus-based flame retardants. During this interaction, phosphorus esters diffuse out of the wires or cables, subsequently forming phosphoric acid on the tube’s surface. This reaction often occurs in cable channels, where PU tubes make direct contact with wires and cables.
Outside of the food and beverage industry, many machine designers might not think about the dangers of microbes building up on the surface of tubing. But microorganisms and biofilms, such as bacteria and fungus, can inflict indirect damage on tubing – especially PU tubes – in the form of metabolic products. In addition to direct microbial degradation, damage can include acid attacks, enzymatic breakdown of plasticizers and an increase in the level of water contained in the plastic (hydrolysis).
In tubing, a polymer’s constituents provide a source of carbon or nitrogen for the metabolic process, ultimately

causing failure in the form of chemical damage or stress cracks. Stress cracks can also occur due to the presence of polar organic substances, including alcohol, ester and ketones.
The resulting internal stress caused by these substances reduces the polymer’s intermolecular forces due to the diffusion of the medium inside the tube. Making matters even more tricky, if tubing contact with the media that had initially caused the stress cracks suddenly stops, then the media diffuses out of the polymer – making it difficult to figure out the root cause of this damage.
Although the majority of tubing damage is the result of environmental influences, you must still factor in possible sources of mechanical damage. For example, a common engineering mistake is to assume a tube can handle sharper corners than it can take, especially in confined areas. But if the tube’s bend radius is reduced, even in static equipment, then the tube can easily kink, weaken and fail—especially if it’s also pressurized.
From a design standpoint, it’s important not to assume your tubing can handle corners – no matter how small – as it can cause the tubing to kink or come up short. In other instances, once a machine begins to cycle, the tubing can snag on or rub against another component or surface. For dynamic situations like this, you’ll need to consider tubing materials that are more resistant to abrasion like PE tubing.
Each type of pneumatic tubing has its different strengths and weaknesses, all which must be balanced with the tube’s environmental and/or mechanical conditions. Keep in mind, however, that not all of these conditions will be obvious—making it extremely important to ask yourself the right questions during the initial design process of your machine. Considering all aspects of your tube’s operating environment will enable you to select the correct polymer and successfully avoid tubing damage, downtime and unnecessary costs. |DE
Randy DeForge is the product manager - Air Supply & Accessories, for Festo Corp.



Many


The fusion of micro molding and 3D printing, through micro additive manufacturing technologies, enhances the capabilities of microscale production and opens up new avenues for innovation.
In the realm of micro molding, precision is paramount. It’s not just about miniaturization; it’s about consistently producing complex shapes to exacting tolerances, measured in microns. Such precision is crucial in applications where the slightest deviation can lead to performance issues.
Concurrently, the rise of additive manufacturing (AM) is beginning to impact production, offering design freedom and rapid iteration capabilities. AM allows for the production of shapes and structures that would be impossible or prohibitively expensive with conventional methods. As 3D printing technologies advance, their integration with micro molding represents a transformative shift in manufacturing.
The fusion of the two, through micro AM technologies, not only enhances the capabilities of microscale production but also opens up new avenues for innovation. Engineers can now experiment with designs that were once unattainable, pushing the boundaries of what can be manufactured and accelerating the development of cutting-edge products.
The integration of 3D printing with micro molding manifests a synergistic relationship that leverages the strengths of both. Micro molding excels at mass-producing parts with incredible precision and allows for the high-volume production of tiny, detailed components.
On the other side 3D printing is celebrated for its rapid prototyping and design flexibility. It bypasses many of the constraints of traditional
the time-to-market for new products can be reduced, facilitating a quicker response to market trends and consumer demands.
This not only serves the needs of fast-paced industries but also fosters an environment of innovation, as manufacturers are able to iterate and refine products with greater agility and less financial risk. The synergy between micro molding and 3D printing is therefore not just a technical improvement but a strategic enhancement to the manufacturing process.
manufacturing methods, such as the need for complex tooling. This combination of technologies enables manufacturers to swiftly move from design to prototype, allowing for comprehensive testing and optimization of parts in a fraction of the time previously required.
The practical outcomes of this fusion are significant. By employing 3D printing for prototyping and even “soft” mold creation or small batch runs, manufacturers can experiment with complex designs and achieve the desired precision without incurring the high costs and time delays associated with traditional mold making.
This streamlined process accelerates the development cycle, ensuring that products can progress from conceptual sketches to tangible parts swiftly. As a result,
The integration of micro AM into the micro molding process yields a significant strategic advantage, particularly when it comes to enhancing market responsiveness. The most conspicuous benefit here is the dramatic reduction in timeto-market for parts produced through this method. Micro AM can produce soft molds in a fraction of the time of traditional steel molds, effectively condensing the product development cycle. This rapid tooling process means that prototypes can be evaluated, refined and approved for production without the usual lag.
This expedited tooling process not only catalyzes the prototyping phase but also propels a quicker transition to production for smaller batches of parts. When parts are needed in the millions, there is no replacement for micro molding at the moment. However, the ability to swiftly produce and modify soft molds aligns perfectly with the dynamic nature of market demands.
As a result, products can be introduced into the market at a pace that keeps up with consumer expectations and competitive pressures.
The implications of this are considerable, offering manufacturers the capability to innovate rapidly, capitalize on emerging trends, and satisfy the ever-shortening windows of market opportunity.
On the prototyping side of things, the use of micro AM technologies significantly enhances the prototyping stage in a conventional high-volume mass manufacturing scenario by enabling rapid iteration and testing of designs, reducing development time and costs.
As already mentioned, micro AM allows for the creation of complex geometries and customized features that are difficult or impossible to achieve with traditional manufacturing methods, enabling engineers and designers to experiment with innovative solutions and
optimize product functionality. Additionally, AM facilitates the direct fabrication of functional prototypes, closely mimicking the properties of the final manufactured parts, thereby improving the accuracy of performance testing and reducing the risk of costly design errors in the mass production phase.
On the production side, micro AM unlocks new business possibilities for manufacturers. Traditionally, they have been restricted by long lead times and expensive micro mold tools.
Using micro AM to produce soft tools opens up the possibility of small, and even medium, batch manufacturing. The platform is able to accommodate the manufacture of multiple small tools in each build, so numerous replacement tools can be
produced at very low cost.
While a traditionally made mold tool for high volume runs may take weeks or months to make and cost thousands of dollars, in the future we may be able to make hundreds of micro-AM produced soft tools. They they will wear out significantly more quickly, but they can be replaced by another soft tool made in hours and costing a few bucks. In addition, each tool can be adapted as required, opening up the possibility of speed to first part out, and the ability to correct during the manufacturing process.
As we look into the future of manufacturing, the continued integration of 3D printing and micro molding promises substantial advancements. This integration is poised to
potentially redefine manufacturing paradigms that have stood for decades. The evolution of materials suited for micro-scale AM, alongside advancements in the technology itself, heralds a future where the complexity of micro molded parts will surge, yet the efficiency of their production will simultaneously increase.
This evolution will drive down costs, making sophisticated micro components more accessible and feasible for a broader range of applications. The manufacturing landscape is approaching an era where the ability to produce complex parts rapidly and cost-effectively will not be an extraordinary feat, but a standard expectation. |DE
Paul Runyan is the VP sales and marketing for Accumold.



AutomationDirect now offers solenoid process valves from GC Valves. The 2-way or 3-way electrically controlled valves support fluids including compressed air, inert gases, coolant and water. The line is available in several styles including zero differential, high-performance, piloted diaphragm and direct-acting valves. They are available in 1/8-inch to 2-inch port sizes; in coil voltages of 24 VAC, 120 VAC, or 24 VDC (12 VDC replacement coil available for select models). Body materials include nylon, stainless steel, and brass; and come in normally open or normally closed styles. Also available are manifold valves that feature a brass or stainless steel manifold, in a 2-, 3-, or 4-station design.
ControlAir LLC introduced its Type 410 pressure regulator, that features a die-cast housing protected with a chromate finish and epoxy paint. Available in 1/4-inch porting, the regulator’s output ranges include 0-2 psig (0-0.15 bar), 0-10 psig (0-0.7 bar), 0-30 psig (0-2 bar), 0-60 psig (0-4 bar), and 0-100 psig (0-7 bar). Exhaust capacity is 0.1 scfm (2.8 Nl/min) downstream pressure 5 psig (0.3 bar) above set point. Sensitivity is 1 inch (25.4mm). Air consumption is less than 6 scfh (170 Nl/min). It also features a wide operating temperature range of 0º to 160ºF (-18º to 71ºC).

primary sensor element, supporting components and a selectable Rosemount pressure transmitter. Designed for measuring process fluids in heavy industry applications, the flow meter has an operating temperature range is -40 to 1,000°F (-40 to 538°C), and the meter is available with Emerson’s Rosemount 3051S Thermal Range Expander for measuring hot or viscous liquids, without the need for heat tracing. Two-way digital connections can be made via 4-20mA HART, WirelessHART, FOUNDATION Fieldbus, Modbus, or BSAP/ MVS. Available line sizes for the sensor are 2-inch to 8-inch (50 to 200mm). All wetted materials are 316L stainless steel, and the meter complies with ASME B31.3 and CRN safety standards.



Mitsubishi Electric Automation, Inc. announced its MELSEC iQ-R Series CIP Safety Module compatible with a range devices, including third-party robots, VFDs, and safety I/O and interlocks. CIP Safety defines a set of rules and mechanisms for exchanging safety-related information between devices in a network. The module occupies a dual slot on an iQ-R PLC rack and is compatible with both EtherNet/IP and CIP Safety protocols. It complies with international safety standards EN ISO 13849-1, Category 4 PL e, and IEC 61508 SIL 3 and has been tested with various third-party robots, PLC peer-to-peer communication, gate switches, area scanners, VFDs, and remote I/O. The iQ-R CIP Safety module is most widely used in packaging and automotive industries but can be applied in systems requiring safe communication.

Emerson has released its Rosemount 9195 Wedge Flow Meter, consisting of a wedge
Endress+Hauser’s Cerabar series pressure transmitters are now offered in both ceramic and stainless-steel measuring cells. The pure ceramic (99.9%) measuring cells offer high resistance to corrosion, minimal temperature hysteresis and the best overload resistance, the company says. They offer measuring ranges up to 40 bar (600 psi max pressure) with a 4 to 20mA output. Designed to withstand harsh conditions, the metallic cell transmitters feature a piezo-resistive sensor and offer measuring ranges up to 400 bar (6,000 psi max pressure) with a 4 to 20mA output.
Moticont released its SDLM-016-032-01-01, a direct drive linear motor with integrated position and temperature sensors. The motor features zero backlash, zero cogging, high acceleration, high speed, high resolution and long life, the company says. Measuring 16.0mm (0.625 in.) in diameter and 31.8mm (1.25 in.) long, the motor also features a linear optical quadrature encoder connected directly to the shaft. Highest throughputs are achieved when the motor is operating at peak efficiency monitoring the temperature from the internal temperature sensor.

Optimal Engineering Systems (OES) unveiled its Allegra Series of stored program motion control systems controllers. Available as a desktop (pictured) or 19-inch rack mount system, the series can be configured for 1, 2, 3, or 4 axes of motion. Commands are written, loaded and saved in the controller’s memory using the supplied free IDE. The controller works with host programs such as: C/C++, Python, Visual Basic, LabVIEW, and MATLAB. The Allegra Series provides up to 7.0A per phase, and up to 256 micro-steps per step resolution, for stepping motors from NEMA 8 to 42; for DC Servos and BLDC servo motors up to 40 Amps per phase, and + 12 VDC to 80 VDC power supply voltage. The series operates on an input power of 115 or 230 VAC, 50-60 Hz, or +24 VDC input

Emerson announced its PACSystems IPC 2010, an industrial computer designed to handle machine and discrete part manufac turing automation applications. The IPC comes with the company’s PACEdge platform and elements of Movicon.NExT SCADA software. Running an industrial version of Linux, the IPC 2010 can be used as a communications gateway and simultaneously, or separately, as an edge computing device. Users can also implement the IPC 2010 as a protocol converter in IIoT, edge, OT/IT convergence, HMI visualization, SCADA connectivity and digital transformation roles. Passively cooled, the IPC features power consumption of four watts and ruggedized packaging.
Mitsubishi Electric Automation, Inc.’s launched its R86T6 teach pendant, designed to deliver customizable and intuitive functions to OEMs and end users. The R86TB features a 10.1-inch high-definition display and the major functions of MELSOFT RT ToolBox 3, Mitsubishi Electric’s PC-based robot programming software. Additional features include data analysis

and real-time monitoring, secure hardware buttons, improved processing speeds and security functions. The R86TB is compatible with the company’s CR800 and CR700 series controllers.




Moxa Inc. has launched line of x86 industrial computers (IPCs) – the BXP, DRP, and RKP series, in multiple form factors and with various Intel processors, totaling 75 different models. Designed for harsh environments, the fanless computers feature a sealed design that withstands operating temperatures between -30 to 60°C. The BXP, DRP, and RKP series offer three form factors based on the installation type, including wall-mount, DIN-rail mount and rackmount options. The lines also feature a variety of interface combinations with up to 12 LAN ports and 10 serial ports. Models in each IPC can be powered by an Intel Atom, Intel Celeron, or Intel Core i5/i7 processor.

Rechner Sensors announced that its capacitive sensor KA1590 from the 26 Series now has IO Link technology. Capable of detecting products with a dielectric constant of 1.1, the sensor comes with normally open contact and normally closed contact. ON and OFF delay timing functions are programmable depending on application requirements. The easy teach by wire is guided by the status of the yellow and green LEDs. The sensor operates on 10 – 35 VDC, the housing is IP67 sealed for CIP (Clean in Place) and installation is via sanitary tri-clamp mounting. Its PTFE housing is FDA 21 CFR 177.1550 compliant for use in food and pharmaceutical applications. The sensor has a temperature rating up to 100°C/212°F. Applications
include level control for batching of powders liquids, bulk solids and pastetype products.

POSITAL announced it has upgraded its 36mm kit encoders. The kit (or modular) encoders are stripped down designs without separate shafts or bearings. Instead, a permanent magnet array is attached directly to the motor’s shaft. The encoders feature TMR (tunneling magneto resistance) for rotational position sensing. According to the company, TMR sensors offer more precise measurement of magnetic field changes, lower temperature sensitivity and lower energy consumption than the Hall effect sensors. They have an 18-bit resolution and are more stable over a wide range of operating conditions. The multiturn variants include an updated ASIC and Wiegand sensors. Every shaft rotation is recorded in the encoder’s non-volatile memory. The line’s protective cover is now 19.3mm high and the number of screws fastening the encoder package to the motor housing has been reduced from four to two. Available communications interfaces include SSI and BiSS-C.

Teledyne e2v has introduced it Flash 2K LSA, a CMOS image sensors adapted for laser profiling applications requiring the use of a Large Scheimpflug Angle (LSA). A derivative of the company’s Flash 2K sensor, the LSA version sports an angular response that has been multiplied more than four times for 30° angles and more than seven times for 40° angles. The Flash 2K LSA shares the same 6µm CMOS global shutter pixel as the other Flash 2K sensors and has the same application-based features such as HDR modes up to 100 dB, multiple Regions of Interest and frame-to-frame on-the-fly changes. Flash is
also available in 2K (2K x 1K, 1,500 fps full frame) and 4K (4K x 1K, 1,800 fps full frame), with or without standard micro-lenses, and combined with or without a glass lid.

Netzer introduce its VLM-60 multi-turn, hollow shaft absolute rotary encoder. The low profile (<8 mm) encoder features 17-bit single-plus-15-bit multi-turn resolution. The master reads the multi-turn positions from the encoder both at start-up and throughout the operation, resulting in smooth and continuous production, the company says. In case of a power outage or a machine shutdown, the VLM-60 maintains the multi-turn absolute position by utilizing an internal battery or an external power source. Resistant to harsh environmental conditions, the encoder is also immune to magnetic fields.

Leuze unveiled its ODT3CL1-2M, a laser diffuse sensor with an operating range of up to two meters. Featuring time-of-flight (TOF) technology, the switching and measuring sensor features background suppression and two independent switching points, which allow it to perform detection and measurement tasks at the same time. Measuring 11.4 x 34.2 x 18.3mm, the sensor is small enough to be used on the gripper of a robot arm, on shuttles or stacker cranes. Its light spot allows fast alignment during commissioning and its operating range can be set numerically via IO-Link.

The RBTX marketplace makes automation accessible

• Rapid return on investment
• Free expert consultations & testing
• Components from various industry leaders
• Guaranteed compatibility across manufacturers












